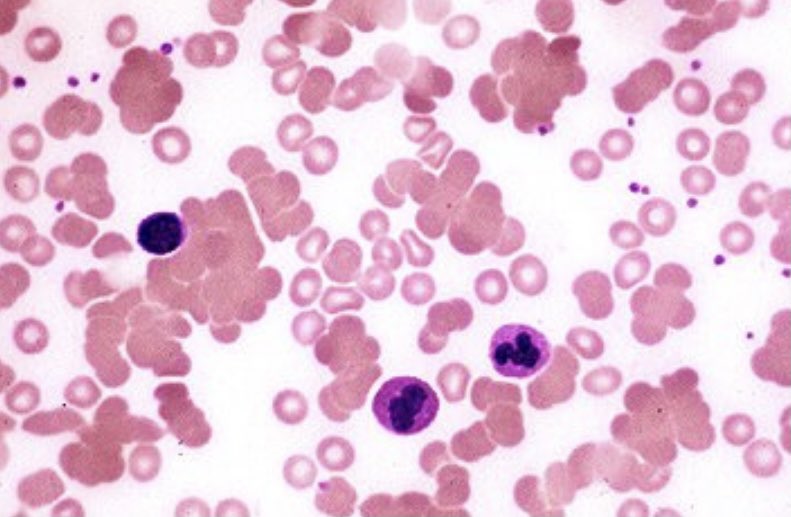
You check hemolysis labs, which show a elevated tbili (indirect predominance), elevated LDH, and low haptoglobin. You diagnose hemolysis as the cause of his anemia. You then check a smear, which shows the following:

It was an icy and chilly one in Philadelphia today, time for a  #MicroMonday. A 21 year old college student living in a dorm presents with 1 week of general malaise, cough, pleuritic chest pain, and fevers. He has +sick contact. CXR shows the following:
#MicroMonday. A 21 year old college student living in a dorm presents with 1 week of general malaise, cough, pleuritic chest pain, and fevers. He has +sick contact. CXR shows the following:
 #MicroMonday. A 21 year old college student living in a dorm presents with 1 week of general malaise, cough, pleuritic chest pain, and fevers. He has +sick contact. CXR shows the following:
#MicroMonday. A 21 year old college student living in a dorm presents with 1 week of general malaise, cough, pleuritic chest pain, and fevers. He has +sick contact. CXR shows the following:
With this limited information, what is the most likely diagnosis?
Likely mycoplasma! This CXR + symptoms are suggestive of an atypical PNA, such as mycoplasma. On CXR you will see reticular nodular opacities or patchy consolidations rather than large or lobar consolidations.
Basic lab work up is unremarkable except for a Hgb of 10/MCV 90. He had a normal Hgb 6 months ago and denies bleeding. What is the next step in work up?
You check hemolysis labs, which show a elevated tbili (indirect predominance), elevated LDH, and low haptoglobin. You diagnose hemolysis as the cause of his anemia. You then check a smear, which shows the following:
What is the most likely cause of his hemolysis?
Yes, cold agglutinin disease! This can be seen with Mycoplasma infections as they induce a change in a RBC antigen  IgM binding
IgM binding  RBCs clumping as seen above in the smear. This ab/antigen complex becomes a signal for the complement pathway
RBCs clumping as seen above in the smear. This ab/antigen complex becomes a signal for the complement pathway  hemolysis.
hemolysis.
 IgM binding
IgM binding  RBCs clumping as seen above in the smear. This ab/antigen complex becomes a signal for the complement pathway
RBCs clumping as seen above in the smear. This ab/antigen complex becomes a signal for the complement pathway  hemolysis.
hemolysis.
This is referred to “cold agglutinin disease” because IgM bind weakly to RBCs at body temperature and more strongly at lower temperatures, usually below 30°C.

 Read on Twitter
Read on Twitter